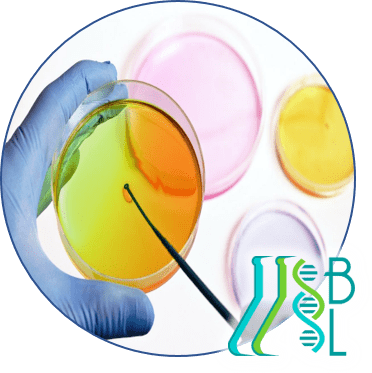

NUESTROS SERVICIOS

Área donde se realiza el aislamiento del o los microorganismos causantes o asociados a una infección.

Área donde se procesan pruebas como tiempo de protrombina, tiempo parcial de tromboplastina, fibrinógeno y pruebas especializadas como factores de la coagulación.

Son análisis que se hacen durante el embarazo para controlar la salud de la madre y del bebe.

Los electrolitos están relacionados con equilibrio de fluidos en las células.

Miden los niveles de enzimas y proteínas que están vinculadas con lesiones del músculo cardíaco.

Es una clasificación de la sangre de acuerdo con las características presentes en los glóbulos rojos y en el suero de la sangre.

Observación macroscópica, microscópica y el análisis químico, parasitológico y bacteriológico de la materia fecal.

En esta sección se efectúa el hemograma y diversas pruebas para evaluar los valores de los distintos componentes de la sangre.

Estudio de la función normal y los desórdenes producidos por alteraciones de las glándulas endocrinas.

Se ocupa del estudio del sistema inmunológico, (enfermedades autoinmunes, hipersensibilidad, inmunodeficiencias, entre otros).

Pruebas que tienen la capacidad para detectar enfermedad renal, del tracto urinario o sistémica.

Abarca múltiples parámetros como la determinación de glucosa, colesterol, triglicéridos, etc.

Es clave para detectar con total precisión la “hormona del embarazo” para confirmar si estás o no embarazada.

Análisis comparativo de los polimorfismos del ADN para determinar o excluir la relación genética

Ayuda a diagnosticar de forma temprana enfermedades y prevenir complicaciones en la salud del bebé
NUESTROS SERVICIOS
Área donde se realiza el aislamiento del o los microorganismos causantes o asociados a una infección.

Área donde se procesan pruebas como tiempo de protrombina, tiempo parcial de tromboplastina, fibrinógeno y pruebas especializadas como factores de la coagulación.

Son análisis que se hacen durante el embarazo para controlar la salud de la madre y del bebe.

Los electrolitos están relacionados con equilibrio de fluidos en las células.

Miden los niveles de enzimas y proteínas que están vinculadas con lesiones del músculo cardíaco.

Es una clasificación de la sangre de acuerdo con las características presentes en los glóbulos rojos y en el suero de la sangre.

Observación macroscópica, microscópica y el análisis químico, parasitológico y bacteriológico de la materia fecal.

En esta sección se efectúa el hemograma y diversas pruebas para evaluar los valores de los distintos componentes de la sangre.

Estudio de la función normal y los desórdenes producidos por alteraciones de las glándulas endocrinas.

Se ocupa del estudio del sistema inmunológico, (enfermedades autoinmunes, hipersensibilidad, inmunodeficiencias, entre otros).

Pruebas que tienen la capacidad para detectar enfermedad renal, del tracto urinario o sistémica.

Abarca múltiples parámetros como la determinación de glucosa, colesterol, triglicéridos, etc.

Es clave para detectar con total precisión la “hormona del embarazo” para confirmar si estás o no embarazada.

Análisis comparativo de los polimorfismos del ADN para determinar o excluir la relación genética

Ayuda a diagnosticar de forma temprana enfermedades y prevenir complicaciones en la salud del bebé
SEGUROS MEDICOS
CONTACTO

NUESTRA OFICINA